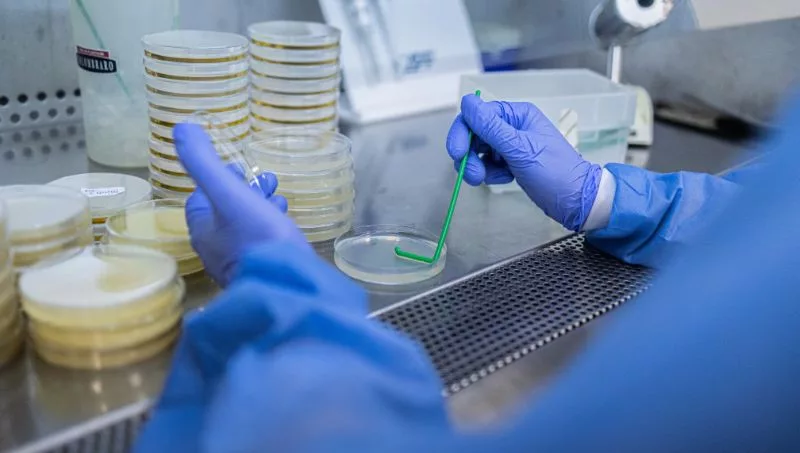

El laboratorio de Tucuman fue un proyecto que arrancó en 2019, nace con el objetivo de fortalecer el sector citrícola.
“Nos posicionamos ahí para estar cerca de la industria, lo que necesita hoy el sector citrícola, hoy estando cerca, aceleramos mucho los procesos, es un punto estratégico donde disparamos a todos los campos” comenta Fernando Garino, gerente de marketing de JLA.
Al principio fueron a visitar clientes de otros rubros como el tabaco y cuando volvieron se encontraron con un polo industrial muy importante, muy similar a lo que es el maní en Córdoba, compara Fernando. Tucumán funcionaba primeramente como una receptoría de muestras que traía el cliente; y desde el año pasado sumaron un laboratorio de microbiología y de residuos.
Hoy en esta sucursal trabajan 8 personas profesionales que está funcionando en su totalidad que dependiendo la temporada del año atiende al tabaco, a los cítricos, a la frutilla, al arándano y/o a las legumbres.
En cuanto al lugar, alquilaron un espacio que tuvieron que readaptar totalmente en el cual tuvieron que hacer una inversión de US$ 700.000. El cual montaron un laboratorio de microbiología totalmente nuevo y movieron un equipo de cromatografía líquido y otro gaseoso de masas para poder atender la parte.
Actualmente JLA tiene 3 sucursales:
-
En Alejandro Roca, dónde tienen un laboratorio que trabaja exclusivamente con maní, con un equipo de 12 personas.
-
En la casa central de General Cabrera con un equipo de más de 140 personas.
-
Y el reciente laboratorio (que inauguraron en 2019) en Famaillá, Tucumán que trabajan 8 personas.
Esto hace un total de 163 personas trabajando el cual, el 70% son profesionales.
Además la empresa tiene convenios con el Conicet para las pasantías, con la Universidad de Río Cuarto, con la de Córdoba y con la Universidad Tecnológica de Tucumán donde ahora ya están trabajando 2 becarios en Famaillá.

Tu opinión enriquece este artículo: